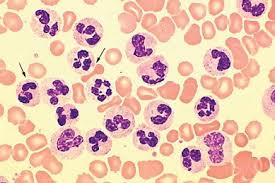

لکوسیتوز چیست؟
لکوسیتوز چیست؟
لکوسیتوز یا (Leukocytosis) بالا رفتن تعداد گلبولهای سفید در گردش خون است. میزان طبیعی گلبولهای سفید ۴۵۰۰ الی ۱۰۰۰۰ گلبول سفید در هر میکرولیتر(LCM) است. گلبول های سفید بخشی از سیستم ایمنی بدن هستند که وظیفه ی آنها مبارزه با بیماری ها و عفونت هاست. درمان این عارضه درمان عامل زمینه ای میباشد.
انواع لکوسیتوز
- نوتروفیلی
- مونوسیتوز
- ائوزینوفیلی
- لنفوسیتوز
- بازوفیلی
علائم لکوسیتوز
- تب
- خونریزی یا کبودی غیر عادی
- ضعف و خستگی
- درد دست، پا یا شکم
- احساس بیمار بودن
- سرگیجه
- اختلال تمرکز و تفکر
- کاهش وزن بی دلیل
- بی اشتهایی
- مشکلات تنفسی
- اختلال دید
دلایل لکوسیتوز
- بیماریهای عفونی
- بیماریهای التهابی مانند آرتریت روماتوئید
- لوسمی یا سرطان خون
- استرس شدید
- آسیب بافت ها ( مانندسوختگی شدید)
- پاسخ سیستم ایمنی بدن مانند در حملات آسم و آلرژی
- اختلالات مغز استخوان
- عوارض جانبی برخی داروها